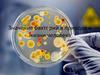
Значение бактерий в природе и жизни человека  (5 класс)

Similar presentations:
История развития зоологии
1.
2.
животноеучение
Что такое зоология?
3.
ЗООЛОГИЯ - наука о животных.Изучает многообразие
животного мира, строение и
жизнедеятельность животных,
их распространение,
связь со средой обитания,
закономерности
индивидуального и
исторического развития.
4.
ЭтологияЗоогеография
Энтомология
Ихтиология
Орнитология
Палеозоология
Зоология
связана
и
с
другими
биологическими
науками,
медициной,
ветеринарией, сельским хозяйством, с
производственной деятельностью человека и
охраной животных.
5.
БуйволОлень
Изображения страусов,
быков, жирафов и
пастухов с луками
Лошадь
Вереница быков
6.
Аристотель(384-322 гг. до н.э.)
• Основоположник
науки
зоологии,
• Сделал
первую
попытку
классификации животных ,
• Подробно описал строение,
образ
жизни
и
распространение более 400
видов животных в своих
сочинениях
«История
животных», «Возникновение
животных»,
«О
частях
животных».
7.
Общий упадок науки в средние векаотразился и на зоологии. Даже
сочинения древних остаются долгое
время забытыми и хранятся лишь коегде в монастырях. Немногочисленные
сочинения этого времени, касающиеся
зоологии, не имеют научного значения.
После ХIII в. наступает период
затишья, но выдающиеся сочинения
переводятся на различные языки;
основываются
многочисленные
университеты в XIV в., книгопечатание
облегчает распространение сочинений
по естествознанию, образуются ученые
кружки,
предшествующие
научным
обществам.
8.
У.Гарвей(1578-1657)
М.Мальпиги
(1628-1694)
А.В.Левенгук
(1632-1723)
9.
К. Линней(1707-1778)
Ж.Б. Ламарк
(1744-1829)
Ж. Кювье
(1769-1832)
Ч. Дарвин
(1809-1882)
10. Палеозоология
А. О. Ковалевский(1840—1901)
И. И. Шмальгаузен
(1884—1963)
А. Н. Северцев
(1866-1936)
И. Мечников
(1845-1915)
К. Бэр
(1792 —1876)
11.
12.
Водная средаНаземно-воздушная
среда
Почвенная среда
Организменная среда
13.
14.
1. Клеточное строение2. Рост
3. Развитие
4. Питание
5. Дыхание
6. Размножение
15.
16.
Пунктысравнения
Строение клеток
Питание
Передвижение
Раздражимость
Рост
Типичное
животное
Типичное
растение
17.
Строение клетки животногоСтроение клетки растения
18.
19. Животные разнообразны по внешнему и внутреннему строению, размерам, образу жизни.
20. Животные , как и растения и все другие живые организмы имеют общие признаки:
21.
22. Сравнительная таблица растений и животных
Разработаныбезвредные
для
человека
биологические методы борьбы с вредителями
сельского хозяйства и запасов продовольствия.
23. 1. Клетки животных не имеют твердой целлюлозной оболочки
Велики достижения в вопросах искусственногоразведения ценных видов рыб.
24. 2. Животные питаются готовыми органическими веществами
Выведеномного
сельскохозяйственных
продуктивность.
пород
животных,
домашних
повышена
и
их
25. 3. Животные могут активно передвигаться
Успешно ведутся работы поодомашниванию
диких
животных.
26.
собольсайгак
бобр
Общепризнаны успехи российской науки в сохранении
животных, находящихся на грани вымирания.
27.
Научныеоткрытия
позволяют
понять
исторического развития животного мира.
ход
28.
Многие особенности строения и жизнедеятельностиживотных изучены и используются в технике.
29.
http://luts.ucoz.ru/load/1/74 иллюстрация с первого слайдаhttp://farm3.static.flickr.com/2601/3914729343_6ba95723dc.jpg вопросительный знак с человечком
http://stefanberanek.fastpage.name/glossaryforscientificanimalnames/ иллюстрация с третьего слайда
http://katandr.ru/prazdniki.html иллюстрация с четвертого слайда
http://puzzle-mania.com.ua/Products/?tags=Standart,3D,Maps зоогеографическая карта
http://www.chexov.info/index.php?option=com_content&task=view&id=552&Itemid=99
http://russian.china.org.cn/photos/txt/2008-06/08/content_15694451.htm
http://gallery.korrespondent.net/world/2458-leto-v-shube-kak-zhivotnye-perenosyat-rekordnuyu-zharu?img=26
http://biology.ru/course/content/chapter10/section3/paragraph8/theory.html
http://blogs.privet.ru/community/zveruchci/55307818 фото поведения животных
http://insects.ucoz.kz/photo/1
http://www.webpark.ru/comments.php?id=50024&ratedown=851270
http://naturewall.ru/photo/106-0-2251
http://tiger.towson.edu/users/lkappe1/symbols%20of%20maryland.htm
http://vport.org.ua/animals/print:page,1,7702-nasekomye.html фото насекомых
http://pda.compulenta.ru/?action=section§ion_id=24201&pageNum=3
http://aquafon.narod.ru/index_2.htm
http://www.ua.all-biz.info/g263561/
http://picture-world.narod.ru/zv/page_33.htm фото рыб
http://www.vitayu.com.ua/index.php?id=363
http://gelik.mylivepage.ru/image/1293_%D0%96%D0%B8%D0%B2%D0%BE%D1%82%D0%BD%D1%8B%D0%B5/lasthttp://lggw550.smartphone.ua/wallpapers_16_2_3.html
http://mp3.multidj.ru/interesnoe-foto-video/print:page,1,62103-foto-ptic.html
http://water-birds.narod.ru/sterna_hirundo.htm
http://mindwar.ru/?m=200812&paged=4 фото птиц
http://www.citizendia.org/Paleozoology
http://unworld.clan.su/news/2010-04-04
http://www.museum.ru/alb/image.asp?12547
http://evosfera.ru/sledi-proshlogo/page_34.html ископаемые остатки животных
http://www.darwin.museum.ru/expos/etap/etap1.htm бюст Аристотеля
30.
http://rec.gerodot.ru/livia/tanakom.htmhttp://genamikheev.livejournal.com/53491.html
http://enc.lib.rus.ec/bse/008/012/900.htm
http://rec.gerodot.ru/livia/tanakom.htm
http://www.darwin.museum.ru/expos/etap/etap1.htm наскальные рисунки
http://www.liveinternet.ru/users/3431020/post167804814/ гравюра средневековья
http://blogs.privet.ru/user/nikkivlad/tags/1470927 портрет А.Везалия
http://www.critical.ru/calendar/2901Lower.htm портрет У.Гарвея
http://www.biographie.net/tag/Membre-de-la-Royal-Society?result_start=30 портрет М.Мальпиги
http://www.krugosvet.ru/enc/nauka_i_tehnika/tehnologiya_i_promyshlennost/LEVENGUK_ANTONI_VAN.html портрет А.Левенгука
http://tvoyrazum.ru/koloniya-i-semya/str_2010-02-28-miniatyurnaya-pastoral-05.html портрет К.Линнея
http://edu.dvgups.ru/METDOC/ENF/HIMIJ/KSE/METOD/KON_S_EST/Nik_3.htm портрет Ж.Б.Ламарка
http://engschool18.ru/schoollife/computer/print:page,1,144-raznoobrazie-zhivotnyx-3kl-shamsutdinova-sg.html
http://dcp.sovserv.ru/humor/9248/2006/07/22/fotomanipulyacii_s_nasekomymi_i_zhivotnymi/print_comments.html
http://www.eurosmi.ru/v_papua_novoiy_gvinee_obnarujeno_50_novyh_vidov_jivotnyh.html http://www.1zoom.ru/10/foto/221355/236.5/
http://www.goodfon.ru/wallpaper/11171.html
http://natureworld.ru/index2.php?option=com_content&task=view&id=601&pop=1&page=0&Itemid=97
http://www.clickmy.name/news/animals?page=5 фото животных с 19 слайда
http://www.drexel.edu/univrel/digest/archive/101006/index.html портрет Ч.Дарвина
http://www.evidenceweb.net/inthemindsofmen/TaylorIMMb02.htm портрет Ж.Кювье
http://ru.wikipedia.org портреты российских биологов
http://www.zastavki.com/rus/comments.php?item=4918 фото тигра
http://downloadmultimedia.com/index.htm?page_number=66&id_pages_nav=1283&tag=%D1%80%D0%B0%D1%81%D1%82%D0%B5%D0%
BD%D0%B8%D1%8F фото розы
http://nadjeeb.wordpress.com/category/bahan-kuliah/ клетка животного
http://schools.keldysh.ru/sch1964/projects/project3/pic/kletka.GIF - растительная клетка
http://www.australiafoto.com/20010603_Phillip_Island_Koala/photo.php3?id=256&id_photo=1506&lang= коала
http://escapio.livejournal.com/93928.html леопард
http://blogs.privet.ru/community/we_love_animals70/80084730 дельфины
http://downloadmultimedia.com/index.htm?page_number=1&id_pages_nav=1283&tag=%D0%9B%D0%BE%D1%88%D0%B0%D0%B4%D0%
B8 лошадь
31.
http://cryazone.com/animals/page/10/ хищная птицаhttp://vlad3066.mylivepage.ru/image/index/last котенок со щенком
http://ihome.ucoz.ru/photo/priroda/zhivotnye/alpaka/11-0-338 лемуры
http://laromakaro.livejournal.com/104127.html мышь-малютка
http://www.vedomosti-ural.ru/interesno/10551/page/22/ синий кит
http://myreptile.ru/forum/index.php?PHPSESSID=5c564779194fca4f2264f3e0edbd06b9&topic=5237.0
http://www.popmech.ru/print/article/3490-sintez-pod-davleniem/
http://www.marchmont.ru/story.php?story_id=11062
http://ns2.onlinemedia.com.ua/jokes/page/15/
http://ekabu.ru/2007/04/18/
http://iov75.livejournal.com/1132924.html фото, иллюстрирующие общие признаки животных с другими живыми организмами
http://www.misflora.com/serv_zashita.html
http://samsay.ru/narodstati/3822-biologicheskaya-borba-s-vreditelyami.html
http://www.tipstricksandreviews.net/nei-pests-in-plants.php биологические методы борьбы с вредителями
http://is.park.ru/print_doc.jsp?urn=42392299
http://www.nrb.su/nrb/category/15 искусственное разведение рыб
http://www.slovar.plib.ru/dictionary/d32/4185.html
http://www.babai.ru/articles/samye-rasprostranennye-porody-domashnih-svinej.html
http://fadr.msu.ru/rin/breeds/horse/horse породы животных
http://lib.rus.ec/b/154563/read
http://forum.zoologist.ru/viewtopic.php?pid=154237
http://skokov.ru/2010/02/03/sumarokovskaya-losinaya-ferma-loseferma-v-kostromskoy-oblasti/ одомашнивание диких животных
http://cetki.com/2010/05/27/kreativnaja_reklama_wwf.html охрана животных
http://pashabr.mylivepage.ru/image/466_%D0%91%D0%BE%D0%B1%D1%80%D1%8B бобер
http://womantalks.ru/lofiversion/index.php/t66612-2250.html сайгак
http://forum.exler.ru/arc/index.php?s=0&showtopic=130987&st=1750 соболь
http://dino.disneyjazz.net/enc4-02.html
http://www.fptl.ru/himija%20jhizni/active-aminokisloti.html эволюция животных
http://graph.livejournal.com/ крыло птицы
http://motodeltaplan.narod.ru/info/varianti.htm дельтаплан
http://hubpages.com/hub/echolocation эхолокация летучей мыши































 biology
biology